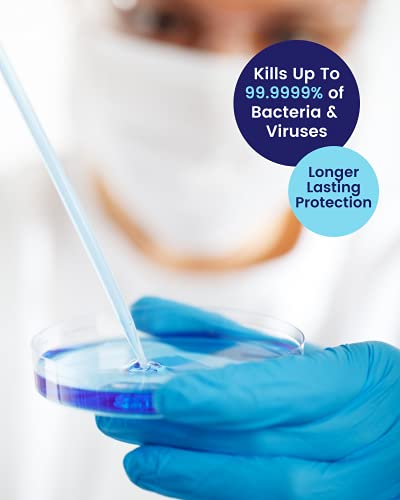

Product Description
The perfect solution to maintaining good hand hygiene whilst travelling! EcoHydra’s hospital grade, alcohol FREE 100ml spray hand sanitiser kills up to 99.9999% of bacteria and viruses quickly and effectively. Containing no harsh chemicals or alcohol means EcoHydra hand sanitisers have no risk of flammability or intoxication, making them suitable for frequent daily use and the perfect choice for children and the most vulnerable. EcoHydra hand sanitisers do not dry, damage or irritate the skin making them ideal for those with sensitive skin or existing skin conditions such as eczema, psoriasis and dermatitis. They protect the skin preventing and controlling any further risk of infection. EcoHydra is also triclosan-free, fragrance-free and remains effective for over 4 hours after application. EcoHydra hospital grade hand sanitisers are NHS approved and trusted by healthcare professionals. EcoHydra is a certified NHS supplier providing hand sanitising solutions for many hospitals across the UK since 2004. EcoHydra hand sanitiser sprays can be used on more than just hands. Spray on surfaces such as trolleys, handles or mobile phones and even spray on your face mask between uses for extra protection. EcoHydra hand sanitisers have passed test standards prEN 12054 (bacteria, yeasts), EN 1276 (bacteria), EN 13704 (bacterial spores), EN 14476 (viruses), EN 1500 (human subjects) and PAS 2424 (residual activity).
Ingredients
Active ingredients: Benzalkonium Chloride 0.1%, Didecyl Dimethyl Ammonium Chloride 0.25%
Safety Warning
For external use only. Do not use in eyes, ears or mouth.
💦 ALCOHOL FREE! – EcoHydra’s fast acting alcohol-free hand sanitiser spray kills up to 99.9999% of bacteria and viruses and contains soothing aloe vera to nourish and moisturise the skin. Perfect for on the go, fits in small bags. Suitable for both adults and children.
🌱 CUTTING EDGE TECHNOLOGY – Using a specific proprietary formula including Aloe Vera, Surfactants and Emollients. EcoHydra Sanitisers combine BASE Technology and ZERO Alcohol to provide a highly effective hygiene solution.
🌿 DERMATOLOGICALLY TESTED – Perfect for those with skin conditions such as psoriasis, eczema & dermatitis. EcoHydra Spray Sanitisers will not sting nor damage the skin on your hands, and is safe for children.
⭐ MULTI-PURPOSE – Our spray sanitisers can be used on any type of surface; tables, chairs, door handles or even your phone. Making trips on the go that much easier!
✔ NHS APPROVED SUPPLIER – EcoHydra products aid in maintaining effective hand hygiene solutions. A certified NHS Supplier providing hand sanitising solutions across the UK.
♥ KILLS VIRUSES, KIND TO SKIN – EcoHydra Products kills up to 99.9999% of bacteria and viruses within 30 seconds of application. Our hand sanitisers have passed EN 1276, EN 1500, EN 14476, prEN 12054, EN 13704 .